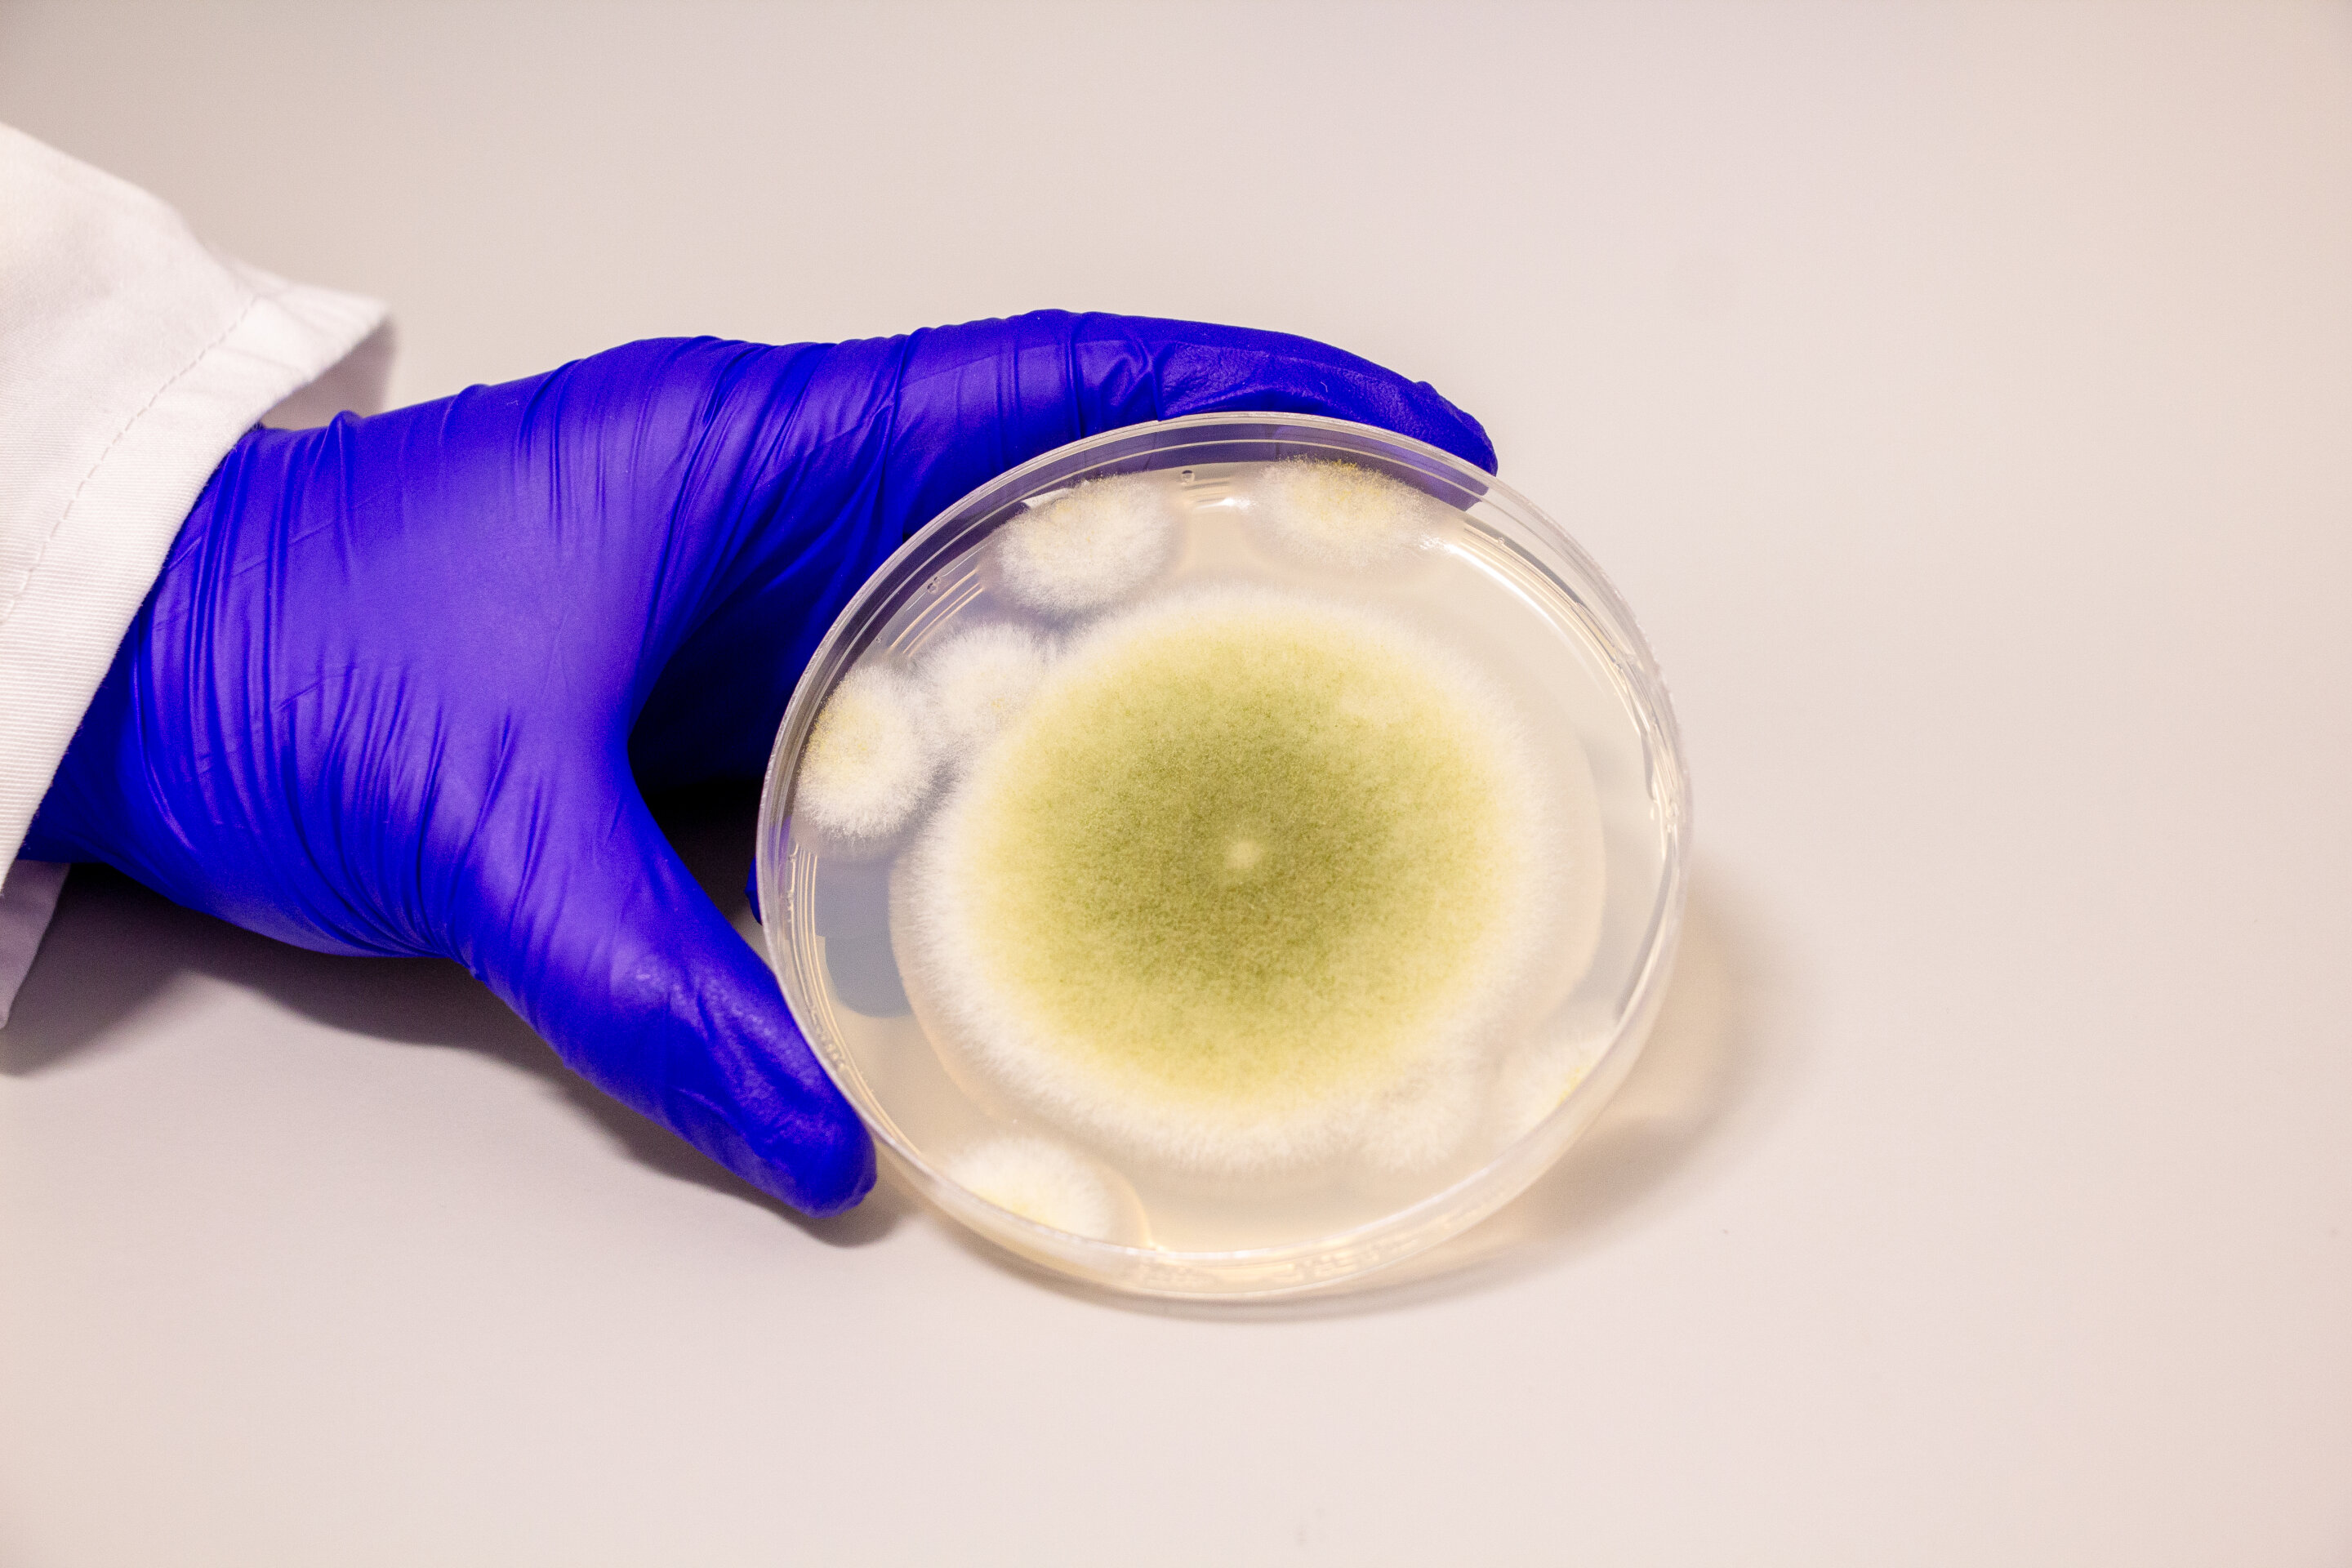

Ancient Tomb Fungus Transformed into Potential Cancer Treatment
A study reveals that the fungus Aspergillus flavus, historically linked to the deaths of tomb explorers, may harbor compounds with potent anti-cancer properties, particularly against leukemia, offering promising avenues for new drug development.